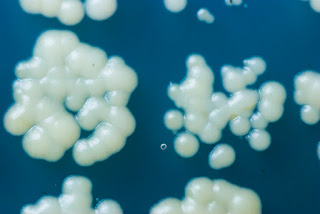

Perdone que no le llame Dra. Salas. A pesar del profundo respeto y admiración que le tengo, en cierta forma, me siento muy cercana a usted. Somos mujeres de ciencia, de Biología Molecular, de bata y poyata, y, sobre todo, luchadoras. Sé que usted tampoco lo tuvo nada fácil, y sin embargo, en un mundo de hombres, usted ha brillado con luz propia.
Nunca perdí la esperanza de conocerla en persona... Me hubiera encantado, aunque seguramente me hubiera pasado lo que me ocurre cuando conozco a alguien a quien admiro y por fin lo tengo delante: solo me sale un profundo “Gracias por su trabajo. Le admiro muchísimo” y me quedo en blanco. Con Van Montagu, otro colega “molecular” nuestro que seguro conoce, ¡¡me dio tiempo hasta de tener una pequeña conversación!!
GRACIAS.
Igual esto lo lee alguien que no es mujer ni se dedica a la Ciencia. Da igual. Todos debemos agradecer su contribución a un campo que cada día tiene más aplicaciones y que nos hace la vida más fácil con multitud de ellas. ¡Quién nos iba a decir cómo ha avanzado la Biología Molecular siendo una ciencia tan joven!
Aunque solo al alcance de algunos, es posible llegar al éxito a lo largo de la carrera científica, pero usted ha sido constante en esa excelencia, no solo con sus propias investigaciones, sino formando a nuevos científicos que hoy en día también brillan y siguen el ciclo de formar a los suyos propios.
Ha llevado el nombre de la Ciencia Española, esa que tan poco valor le damos en nuestro propio país, fuera de este, traspasar fronteras y que la consideremos nuestra “Marie Curie nacional”. Qué cosas… se ha ido el mismo día que llegó ella a este mundo. La Ciencia que se hace en nuestro país es de calidad a pesar del mal trato que recibe. Usted siempre nos apoyó y lo gritó a los cuatro vientos.
Gracias por hacer suyas y compartir con la sociedad estas palabras de Severo Ochoa defendiendo la investigación básica de calidad. "Hay que hacer investigación básica de calidad y hay que dejar al investigador libertad para hacer su investigación, porque de esta investigación básica saldrán resultados que no son previsibles a priori y que redundarán en beneficio de la sociedad".
Gracias, Margarita, por defender el papel de las mujeres en la Ciencia. Lo ha vivido usted misma en sus comienzos y ha experimentado lo difícil que es a veces ganarse el respeto incluso de nuestros propios compañeros. Usted estaba convencida de que llegará un momento en que la mujer científica ocupe en la ciencia el lugar que le corresponda. Yo también espero verlo. Luchamos porque así sea.
Gracias, porque a pesar de haber podido disfrutar de un descanso bien merecido y poder disponer de un tiempo que es casi inexistente cuando te dedicas en cuerpo y alma a la Ciencia, ha elegido seguir con la bata puesta, dándolo todo hasta el final. Probablemente lo haya hecho porque es motivador enseñar a los más jóvenes. Su experiencia es oro (¡qué no hubiera dado yo por conocer sus opiniones en tantos aspectos o preguntarle dudas de esas que hay miles cuando las cosas no nos salen bien en el laboratorio!). O tal vez porque cuando amamos lo que hacemos no nos importa invertir tiempo en eso. O porque, simplemente, siempre estamos aprendiendo e ilusionándonos y, para eso, nunca nos jubilamos.
Nunca perdí la esperanza de conocerla en persona... pero eso ya no podrá ser. Lo que sí puedo hacer es darle las gracias a mi forma, eso sí. Y tratar de transmitir un legado inmenso por el que hoy en día los investigadores españoles nos sentimos orgullosos. Yo, como científica, hoy me siento un poquito más sola.
Nos enseñó que el sentido de la vida es de 5´a 3´ pero para usted, el sentido de la vida fue realmente la Ciencia.
Buen viaje, Margarita.
Margarita Salas ha sido una de las científicas españolas más importantes del siglo XX-XXI. Fue discípula de Severo Ochoa con quien trabajó durante su postdoc en Nueva York después de hacer la tesis doctoral con Alberto Sols en Madrid.
Sus aportaciones científicas son numerosas y de gran valor destacando la determinación de la direccionalidad de la lectura de la información genética (5' → 3') y el descubrimiento y caracterización de la ADN polimerasa del fago Φ29, con altísima capacidad de amplificación del ADN. Margarita aisló este enzima y demostró que funcionaba en las células humanas, marcando el comienzo de aplicaciones innovadoras para las pruebas de ADN, usándose en áreas como la medicina forense, oncología y arqueología, entre otras. De hecho, este descubrimiento se tradujo en una patente que se ha convertido en una de las más rentables del CSIC. Entre 2003 y 2009, según el CSIC, más de la mitad de los derechos de autor ingresados por el Consejo los obtuvieron gracias a la patente de Margarita Salas y su equipo.
Ha pertenecido a varias de las más prestigiosas sociedades e institutos científicos nacionales e internacionales, colaborando y siendo miembro del consejo editorial de importantes publicaciones científicas. A lo largo de su carrera, Margarita Salas recibió numerosos premios internacionales y nacionales, entre los que se encuentran la Medalla Mendel, el Premio Rey Jaime I, el Premio Nacional Ramón y Cajal, el Premio L’Oreal UNESCO y la Medalla Echegaray. Salas fue además miembro de la Academia Nacional de Ciencias de Estados Unidos, convirtiéndose así en la primera mujer española que entra a formar parte de la institución, y miembro de la Real Academia Española, donde ocupó el sillón i. Presidió la Fundación Severo Ochoa y fue doctora honoris causa por varias universidades